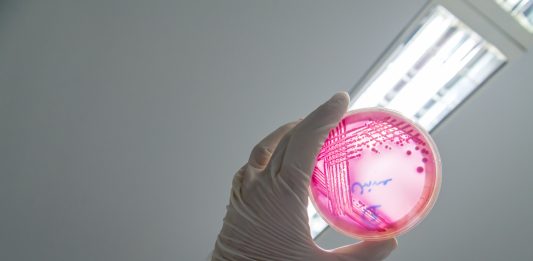

Behörden alarmiert: Häufung von EHEC-Infektionen unter Kindern und Jugendlichen
SCHWERIN. Das vermehrte Auftreten von EHEC-Infektionen bei Kindern hat die Behörden in Mecklenburg-Vorpommern alarmiert. Mindestens vier werden aktuell auf Intensivstationen behandelt. In Mecklenburg-Vorpommern gibt es eine Häufung von EHEC-Infektionen bei Kindern. Aktuell sind (Stand Freitag) 17 Menschen, die meisten davon Kinder und Jugendliche im Alter zwischen 1 und 15 Jahren, erkrankt. Mindestens fünf von ihnen weisen … Behörden alarmiert: Häufung von EHEC-Infektionen unter Kindern und Jugendlichen weiterlesen
1 Kommentar